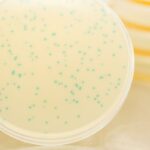
Phages faqs photo

E. coli Bacteriophages E. coli is a commonly known pathogen, but many are unaware of its specific variants. Avian pathogenic E. coli, or APEC, poses a significant threat to both the poultry industry and public health. As resistance to antibiotics continues to spread, alternative methods of controlling APEC infections are needed – give preference to …
News and events
Salmonella phage CKT1 significantly relieves the body weight loss of chicks by normalizing the abnormal intestinal microbiome caused by hypervirulent Salmonella Pullorum
Salmonella phage CKT1 and Salmonella Pullorum While conventional antibiotics have long been used to control Salmonella pullorum infections in poultry, concerns about drug resistance have led to research into alternative methods. This is where phage therapy comes in – the use of bacteriophages, or viruses that specifically target and infect bacterial cells, to treat bacterial …
The gut microbiota of chickens in a commercial farm treated with a Salmonella phage cocktail
Salmonella phage cocktail The health, metabolism and immunity of broiler chickens can be strongly influenced by the microbiota in their gut. Certain bacteria can have a positive effect, while others have a negative impact on animal productivity. Therefore, new strategies to control pathogens without upsetting the delicate balance of the microbial community are critical. Phages, …
A therapeutic approach in animal health with bacteriophages – Phagovet
Phagovet: bacteriophages In recent years, a new approach to treating infections in animals has gained importance – phage therapy. Bacteriophages or phages are viruses that specifically target and infect bacterial cells. Phage therapy offers several advantages over conventional antibiotics. First, each phage is highly specific to its bacterial host, so it is less likely to …
A therapeutic approach in animal health with bacteriophages – PhagovetRead More
Characterization of Clostridium perfringens bacteriophages and their application in chicken meat and milk
Clostridium perfringens bacteriophages in poultry Clostridium perfringens is a major cause of foodborne illness and poses a significant threat to public health and economic success in developed countries. In response, researchers have turned to an age-old solution: Bacteriophages. In a recent study, 19 C. perfringens and 6 C. perfringens-targeting bacteriophages were isolated from chicken samples. …
Characterization and genome analysis of a broad lytic spectrum bacteriophage P479 against multidrug-resistant Escherichia coli
Broad lytic spectrum bacteriophage P479 against multidrug-resistant Escherichia coli The increase in antibiotic resistance in pathogens such as E. coli poses a major challenge for the treatment of infections. Fortunately, bacteriophages offer a promising alternative to combat these resistant strains. Studies have found that the phage P479 is capable of lysing multiple serotypes and drug-resistant …
Phages: commonly asked questions
Frequently asked questions about phages 1. What are phages? Phages are viruses that infect and kill bacteria. They are the most abundant organisms on earth and can be found in almost any environment, including the human gut. Phages are specific to the bacteria they infect and do not harm other cell types, such as human …
Productive Performance and Cecum Microbiota Analysis of Broiler Chickens Supplemented with β Mannanases and Bacteriophages – A Pilot Study
Broiler Chickens Supplemented with β-Mannanases and Bacteriophages The objective of this study was to investigate the effects of supplementing broiler diets with Mn and BPs on production performance, gut health, and appendix microbial communities. Results showed that supplementation with Mn and/or BPs had similar effects on productivity as the antibiotic control group while improving immune …
Gastrointestinal Dynamics of Non-Encapsulated and Microencapsulated Salmonella Bacteriophages in Broiler Production
Salmonella Bacteriophages in Broiler Production In the search for new ways to combat harmful bacteria, the use of bacteriophages – viruses that specifically attack and destroy bacteria – is becoming increasingly important in the poultry industry. However, researchers have found that oral administration of phages can be difficult because different conditions in the gastrointestinal tract …
Application of Bacteriophages to Limit Campylobacter in Poultry Production
Bacteriophages to Limit Campylobacter in Poultry Production It may surprise you, but in our bodies and in nature there is a microscopic army that is constantly at war – viruses that attack bacteria. Bacteriophages or phages are viruses that specifically attack and eliminate bacteria. This makes them a potential tool for controlling harmful bacterial populations …
Application of Bacteriophages to Limit Campylobacter in Poultry ProductionRead More
Non-Antibiotics Strategies to Control Salmonella Infection in Poultry
Salmonella infections in poultry Salmonella spp. may not be familiar to everyone, but it is a widespread pathogen that causes localized or systemic infections with economic and public health significance. Unfortunately, this bacterial pathogen, which is commonly transmitted by poultry, remains a major cause of food safety problems worldwide. For many years, the main strategy …
Non-Antibiotics Strategies to Control Salmonella Infection in PoultryRead More
Spontaneous Phage Resistance in Avian Pathogenic Escherichia coli
Phage Resistance – Escherichia coli The emergence of multidrug-resistant bacterial pathogens has led to a need for new therapeutic options, and the use of bacteriophages, also known as phages, has become an interesting option. However, there is concern that phage-resistant mutants could rapidly evolve, compromising the efficacy of phage therapy. In a recent study, scientists …
Spontaneous Phage Resistance in Avian Pathogenic Escherichia coliRead More